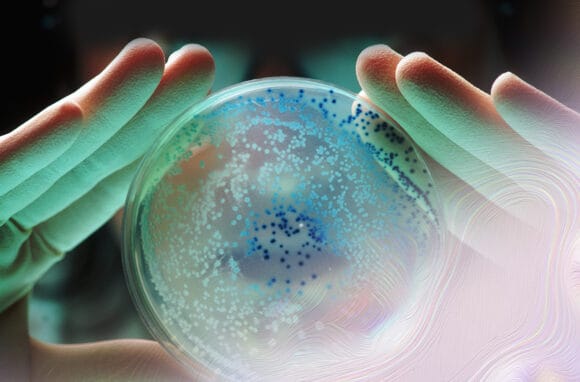

Partnering to redesign our world
Our enterprise biology platform, nth Bio by Perfect Day, is the first of its kind to help partners of all sizes create a kinder, greener future through precision fermentation.
The potential is exponential.


Scaling our science for more of us
Our enterprise biology innovation arm, nth Bio, is focused on piloting and scaling our technology to partners across industries, including food, agriculture, pharmaceutical, biologics, textile, and personal care to create products in a new, sustainable way.

Creating space to share our knowledge
Partners who work with nth Bio have access to our expertise and experience in biotech, food and consumer packaged goods.

Supporting our unique ambitions
Shifting to resilient production methods that can optimize constantly allows us take chances, make mistakes, and grow together. With nth Bio, partners make kinder, greener products quickly and cost-effectively, and learn as they go.
Perfect Day Raises $350 Million to Expand Consumer and Enterprise Biology Platforms
Capabilities
Optimized Strain Engineering & Screening
Upstream Process Development
Downstream Process Development
Nimble Piloting
Faster Regulatory Filing
Flexible Manufacturing
Shape the future, from strain to scale.
It’s time to unlock the power of precision fermentation to create and scale new, sustainable supply chains.